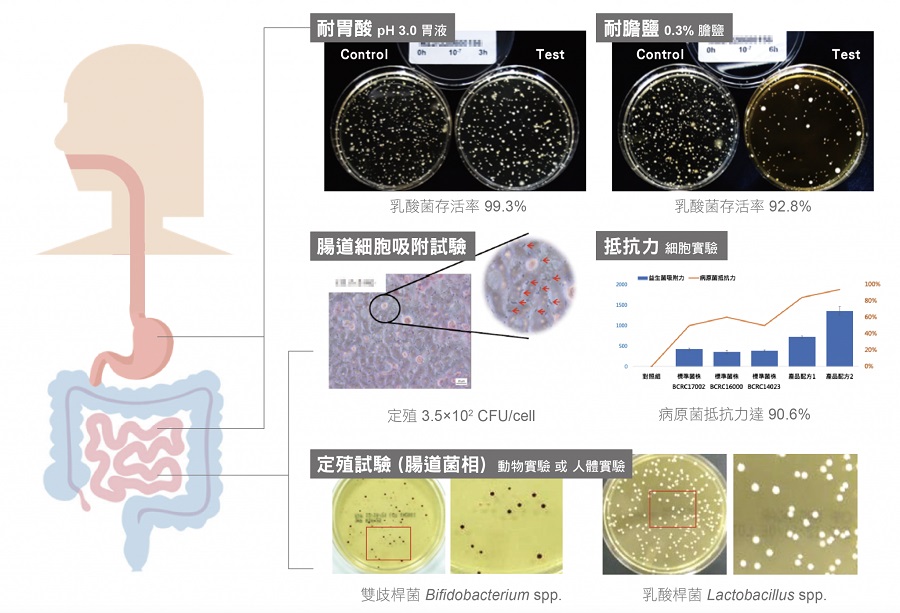
益生菌檢驗
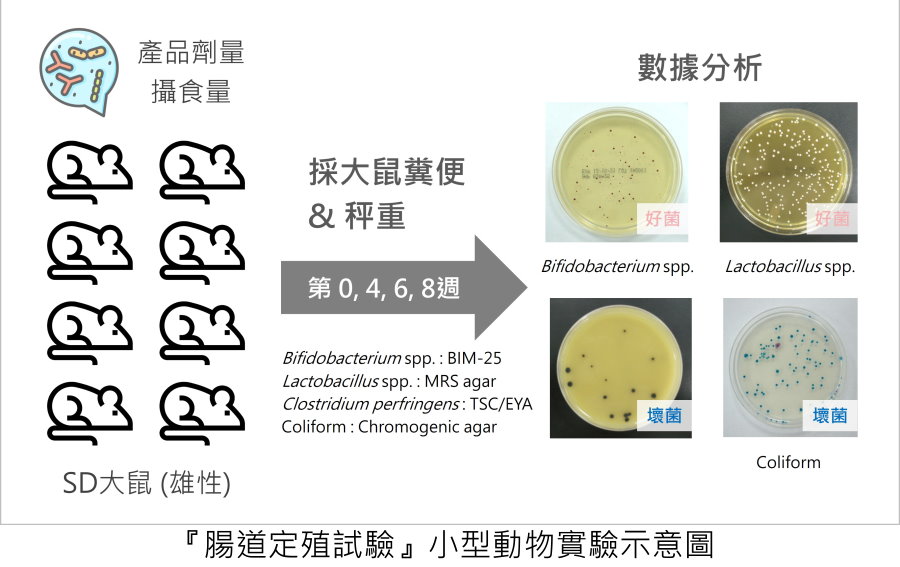

大家都知道益生菌好處多多,之前大口研究了好幾款優質的益生菌,當時也有這個疑問,不知道吃進去的益生菌到底有沒有效果,畢竟很難用肉眼辨識出來;而益生菌真正有效的驗證方式,就是經過耐胃酸、耐膽鹽、定殖力檢驗,就能篩選出高存活率的優質菌株,對產品來說更有說服力,對消費者來說服用效果也更好。
▼大家都知道益生菌可以使排便順暢、幫助維持消化道機能,更能調整體質、健康維持,加上疫情的影響,大家對於益生菌的需求也越來越高,但是對於益生菌的了解卻相當有限,只知道益生菌對身體有好處,但也不確定吃進肚子裡的益生菌到底有沒有效果,就是一個吃心安的路線~~現在大家都講求錢要花在刀口上,要了解自己吃進去的益生菌產品到底有沒有真正在腸道裡發揮功用才是最重要的!

▼為什麼腸道如此重要呢?因為除了掌管消化及排便功能之外,也是人體內最大的免疫系統,腸道內的細菌是由5000種細菌所組成,可以用來分解食物、消化並產生營養素,成為人體能量來源;但要如何確保服用的益生菌可以順利在腸道中產生效果呢?以下幫大家整理幾個重點:
1.益生菌必須通過胃酸、膽鹽的考驗,確保能順利抵達腸道並保持活性。
2.菌株需成功定殖在腸道黏膜,並有良好的生長環境幫助持續複製繁殖。
3.獲得檢驗認證,合法確保安全性與功效性。

▼在益生菌產品製造的前期,廠商應先進行產品自我把關,確認自身產品中益生菌實際保有活性之菌種菌量,並委託第三方公正機構進行指定菌種檢驗,才不會經過抽驗後,發現實際上菌種、菌數含量與標示不符合之情況,讓消費者對產品及品牌都失去信心。

▼益生菌要怎麼通過身體自我防衛的胃酸、膽鹽呢?這時候就得依賴產品製造時的包埋技術,或是特殊耐酸菌種,讓菌種可以耐酸耐鹼,不受胃酸、膽鹽的破壞,等到菌種順利抵達腸道後又是另外一種考驗的開始,必須要穩定吸附在腸道上才能快速增殖,加上腸道本來就有很多好菌、壞菌,所以在吸附環境的競爭下也是決定菌種生存的關鍵。(圖片取用自台美檢驗)
▼對於益生菌來說,最有效的驗證方式就是定殖力的測試,也就是指好菌可以在腸道生存下去並繼續繁殖,如果能夠通過腸道定殖試驗,就能為產品申請健康食品認證,同時也能替消費者服用益生菌的效果把關!
▼「台美檢驗」不僅提供定殖試驗,還有替產品加值的安定性試驗與耐性試驗,此外還可以模擬消費者保存與使用方式,像是消費者每天服用,開罐次數頻繁,或是存放的特殊條件不太一樣,都能確保產品在這樣的環境下仍能維持良好品質,降低風險並提升產品本身的安全性,這才是消費者安心的保證!

最近才認識到這間「台美檢驗」,他們專為產品把關,透過定殖試驗、安定性試驗與耐性測試,來幫大家驗證產品的安全性,可靠度也會大大提升不少!「台美檢驗」是台灣檢驗公司中唯一橫跨醫學、化學及生物領域的第三方公正檢驗機構,也是台灣政府機關所認證的實驗室,表現屢獲國內外認可,在益生菌解決方案更是有獨到之處~~且大家都知道益生菌買起來都不便宜,重點有效果才是最重要的!有了「台美檢驗」的檢驗把關,不僅讓消費者對於益生菌產品更有信心,而且還能吃得有效果,有興趣的朋友不妨可以參考!
【相關資訊】
台美檢驗
官網:https://www.superlab.com.tw/
FB粉絲團:https://www.facebook.com/superlab/




